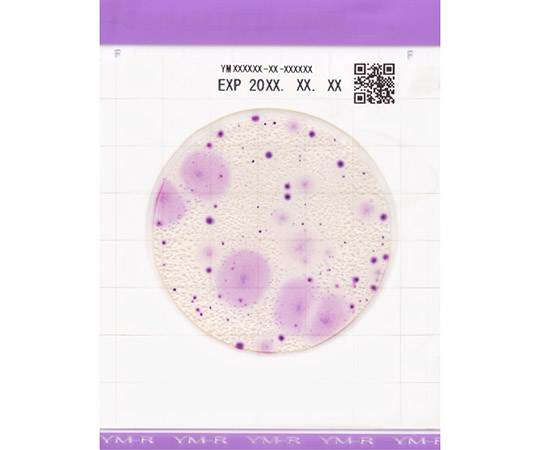

アズワン 年度末大感謝SALE 2025 対象品!2026年03月31日 受注分まで!
| Airis1.co.jp | 658-4817-079 |
|---|---|
| アズワン | 4-5420-05 |
| 消費税区分 | 標準税率(10%) |
|
16,896円(税込) ※実際の消費税は消費税区分別にて算出されます |
Easy Plate 真菌(カビ・酵母)数測定用(25枚/袋×4袋入) YM-R 61977 61977(1箱(25枚×4袋入り))
商品
特徴
●粉末培地の調製や事前のオートクレーブ滅菌が不要で、不意の検査にもすぐに対応できます。●寒天培地より短時間で測定が可能です。●コロニーは紫色に発色します。(カビ:大きく広がり周囲が明瞭でないコロニー、酵母:明瞭な真円に近いコロニー)●培養時間は48時間、ポテトデキストロース寒天培地(120時間)に比べて検査の迅速化が可能です。●食品残渣がある場合でもコロニーの判別、カウントが容易です。●AOAC PTM認証・MicroVal認証・NordVal認証を取得しています。●無料のソフトウェアと指定スキャナー(ADS-4300N、品番:65-9217-51)で、コロニーの自動カウントが可能です。●自動カウントにより、業務の効率化に加えて、作業者によるバラつきや熟練度の影響も解消されます。
仕様
●型番:YM-R●真菌(カビ・酵母)数測定用●入数:1箱(25枚/袋×4袋入)●使用期限:製造から18ヶ月●培養温度:25°C±1°C●培養時間:48時間±2時間●AOAC PTM認証・MicroVal認証・NordVal認証取得●※保管温度:2~8°C●※発色が不明瞭な場合は24時間の追加培養を実施ください。●※開封後は袋の端を2回以上折り返してテープで止め、冷蔵保存の上、1ヶ月以内に使用してください。●※本品は日本国内向けのみの販売となります。●フィルム培地
個人宅宛の配送について
※配送先が個人宅宛の場合、 ご注文のキャンセル又は出荷まで+3営業日ほどお時間をいただく場合がございます。
| 商品コード | 658-4817-079 |
|---|---|
| 型番 | 61977 |
| 入数 | 1箱(25枚×4袋入り) |
| 標準価格 | |
| 割引率 | -2,140円 (12%) |
| WEB価格 | 15,360円(税抜) |
| 在庫数 | 取寄品 |
| 出荷目安 | お問い合わせください |